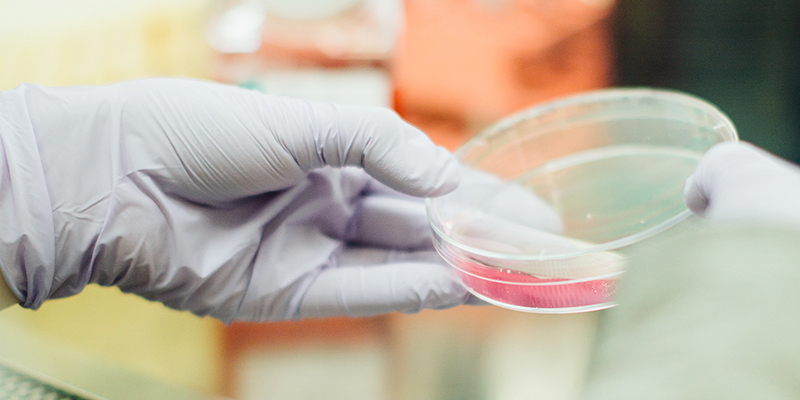
Infertility test results-Jeevan Infertility-test-results-Jeevan

Male infertility test results help you to detect infertility in men. The Male infertility test procedure involves semen analysis. Almost half of the current fertility problems are male, and abnormal sperm production or function is generally the cause. It will be a thriller climax when you sit before your fertility specialist when she says that the report looks a little not ok.
The fertility specialists will want to examine the semen analysis results to identify the exact issue if abnormal semen analysis is identified to be the cause of infertility.
WHAT IS AN ABNORMAL SEMEN REPORT:
If the semen volume, sperm count, sperm morphology, or sperm motility do not meet medical requirements, a semen analysis could result in an abnormal result.
The common abnormalities noted are:
- Azoospermia-Absence of sperm in the ejaculate. Almost 10 -15% of infertile men suffer from this problem.
- Aspermia-Complete lack of semen with ejaculation(dry orgasm).
- Oligospermia-This is the most common reason for infertility in men. Depending on the severity, it is categorized into mild, moderate, and severe.
- Asthenospermia or Asthenozoospermia– When there is reduced sperm motility, it is called asthenozoospermia.
- Teratozoospermia– Sperms with abnormal sperm morphology. The sperm may have an abnormal head, midpiece, or tail.
- Necrozoospermia or Necrospermia-When the majority of sperm is dead(necrotic). The percentage of living spermatozoa is less than 58%.
- Hypospermia– When the total ejaculate is low in a volume of less than 1.5 ml
- Pyospermia-When a large number of white blood cells are in semen. It is also called leukocytospermia
WHAT YOU SHOULD DO:
The normal and abnormal ranges are based on percentiles. The percentile means the percentage of men with that particular result who was able to be the father of a child in one year. So, don’t panic if your results are abnormal. A normal semen result doesn’t guarantee fertility and subnormal results don’t mean that you will never be able to be the father of a child. There are lots of other factors influencing the fertility of men.
Apart from treatment from fertility specialists have a change in your lifestyle to improve your sperm health
- Reduce your stress
- Have a healthy diet
- Reduce alcohol intake
- Quit smoking
- Exercise
- Minimize exposure to environmental dangers/toxins
TO CONCLUDE:
Male infertility test results help you to detect sperm health. Discuss with your fertility specialist about your abnormal result and hopefully go for further management. There is always a window open if a door is closed. Follow the advice of your fertility specialist and have a happy pregnancy journey with your partner.